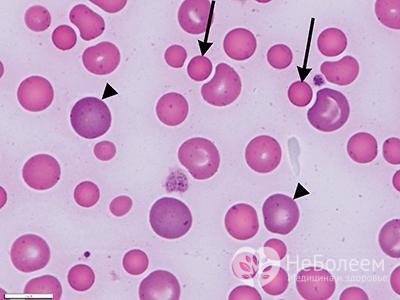

Что такое RDW в анализе крови
Что такое RDW в анализе крови
Эритроциты в крови человека не одинаковы по размерам. Для обозначения степени этой гетерогенности существует специальный индекс – RDW (дословно в переводе «ширина распределения красных клеток») или индекс анизоцитоза эритроцитов. Под термином анизоцитоз подразумевается одновременное присутствие в крови красных кровяных телец со значительным колебанием размеров. То есть, RDW показывает, насколько разнообразны объемы эритроцитов в исследуемом образце.
Как определяется RDW?
Определение данного индекса проводится гемоанализатором автоматически по специальной формуле, в которой учитывается средний объем красных клеток крови и среднеквадратичное отклонение от него размеров эритроцитов. Рассчитанный таким образом показатель принято обозначать RDW-CV, единицы измерения – проценты. Норма – 12-15%. RDW-CV зависим от среднего объема эритроцитов, поэтому если большинство из клеток будут мелкими (как при микроцитозе), показатель останется в пределах нормы.
Также в результатах анализа крови можно встретить и аббревиатуру RDW-SD. Этот показатель определяется по другой методике (по эритроцитарной гистограмме) и не зависит от среднего размера эритроцитов.
Измеряется RDW-SD в фл (фемтолитрах) и отображает разницу между максимальным и минимальным объемом красных клеток в исследуемом образце. Норма 35-60 фл. Стоит также отметить, что RDW можно определить и по гематологическому мазку, однако это тяжелее, дольше и чаще дает ошибочные результаты.
В каких случаях врачу необходимо знать величину индекса анизтоцитоза?
Ширина распределения эритроцитов обязательно определяется при проведении клинического (развернутого) анализа крови. Это необходимо врачу для правильной интерпретации результатов исследования, диагностирования и дифференциации анемий, поскольку информации лишь о количестве красных кровяных клеток и концентрации гемоглобина недостаточно (изменения этих параметров дают только общие сведения о наличии малокровия).
Расшифровка величины RDW в анализах всегда проводится параллельно с оценкой среднего объема эритроцитов (MCV), так как довольно часто ширина распределения красных кровяных клеток остается в норме при наличии микроцитоза или макроцитоза, которые являются патологическими признаками.
Причины повышения индекса анизоцитоза
Если RDW в анализе крови повышен, у больного можно заподозрить следующие патологические состояния:
- Железодефицитную анемию. Причем показатель ширины распределения эритроцитов может вырасти еще до появления изменений со стороны красных кровяных клеток и гемоглобина, то есть повышенный индекс анизоцитоза можно назвать ранним маркером анемий;
- Гемолитическую анемию иммунного характера;
- Мегалобластную анемию (при нехватке витаминов В9 и В12);
- Гемоглобинопатии.
Клинический анализ крови с завышенным значением показателя RDW также характерен для пациентов, страдающих недугами печени, перенесших переливание крови либо лечение различных нутрициональных нарушений. Кроме того, индекс анизоцитоза может быть завышен и ложно, если в исследуемом гематологическом образце присутствуют холодовые агглютинины.
Помимо этого, во время лечения железодефицитной анемии показатель RDW не только не уменьшается, но и повышается, но при этом заметно меняется гистограмма (на кривой появляются два пика). Это связано с тем, что в сосудистое русло попадают молодые, отличающиеся от зрелых кровяных телец клетки. Если медикаментозная терапия оказывается эффективной, индекс анизоцитоза все-таки нормализируется, но самым последним из всех определяемых индексов. Также стоит отметить патологии, при которых RDW не меняется. К ним относятся: бета-талассемии, малокровие при тяжелых хронических заболеваниях, серповидно-клеточная анемия, острые геморрагические и апластические анемии, сфероцитоз.
Стоит также рассмотреть ситуации, при которых RDW в анализе крови понижен. Если при этом показатель отклонен от нормы незначительно, и нет других изменений в результате исследования, то беспокоиться не стоит. То есть, такой анализ считается вполне нормальным и просто показывает, что большинство эритроцитов имеют размеры, максимально приближенные к средним значениям. Если же величина индекса значительно ниже нормы, что встречается редко, необходимо дальнейшее обследование.
Объем эритроцитов в крови нормы и отклонения
Норма RDW для взрослых вне зависимости от половой принадлежности, колеблется в пределах 11,5–14,5%. У детей результаты теста могут значительно отличаться, на этот показатель влияет множество факторов, в том числе приспосабливание малыша к жизни. Изменить норму эритроцитов способен сильнейший стресс, испытанный новорожденным во время родового процесса.
Для грудничков, показатель RDW не должен выходит за рамки 14,9–18,7%. По мере взросления, фиксируется естественное изменение количественного состава эритроцитов. Так, к 6 месяцам общепринятой нормой считается 11,6–14,8%. Постепенно показатель приближается к «взрослой» отметке и при нормальном состоянии организма остается неизменным.
Внимание: о наличии нарушений или пагубных процессов, свидетельствует отклонение, превышающее 15% от общего количества кровяных телец. В этом случае опытный специалист назначает дополнительный комплекс исследований, направленный на выявление первопричины изменений в большую или меньшую сторону
В этом случае опытный специалист назначает дополнительный комплекс исследований, направленный на выявление первопричины изменений в большую или меньшую сторону.
О чем говорят пониженные значения
 Поскольку оценить RDW без MCV полноценно невозможно, следует рассмотреть все варианты пониженных значений при взаимосвязи этих двух индексов:
Поскольку оценить RDW без MCV полноценно невозможно, следует рассмотреть все варианты пониженных значений при взаимосвязи этих двух индексов:
- RDW низкий, а MCV ниже среднего – проблема с печенью и селезенкой.
- RDW низкий, а MCV больше нормы – наличие онкологических заболеваний, преимущественно с метастазами в костном мозге.
Снижение уровня распределения эритроцитов не может проявляться в принципе, если рассматривать этот показатель с биологической точки зрения. Поэтому в медицинской практике при выявлении довольно низких значений в 99,9% всех случаев пациенту предлагают пересдать кровь, выполнив предварительно все условия:
- не курить и не употреблять алкоголь за 24 часа до забора крови;
- не использовать медикаменты перед анализом;
- ограничить потребление соленой и копченой пищи накануне.
В том случае, когда RDW действительно ниже нормы, что подтверждается неудовлетворительными анализами его «коллеги» MCV, это может свидетельствовать о развитии таких заболеваний, как:
- Микроцитарная анемия – в простонародье «малокровие», когда из-за неправильных форм эритроциты быстро отмирают, не являя собой никакой биологической ценности для организма.
- Злокачественные новообразования – обычно касается таких заболеваний, как мастопатия, рак костного мозга и рак легких.
- Обширный гемолиз – процесс, при котором эритроциты разрушаются еще до того, как достигнут своей цели. В результате высвобождается активный гемоглобин.
Причины
 Выделяют ряд причин, которые могли бы спровоцировать развитие подобного проявления, как пониженный RDW:
Выделяют ряд причин, которые могли бы спровоцировать развитие подобного проявления, как пониженный RDW:
- Большая потеря крови при травматизме и патологических кровотечениях. Наиболее опасными являются маточное и желудочное внутреннее кровотечение, при которых кровь уходит быстрыми темпами, снижая шансы на выживание.
- Частые хирургические вмешательства, особенно при удалении какого-либо органа или его части.
- Неправильный обмен веществ, при котором потребляемая пища полностью не переваривается и не усваивается, а частично или полностью подвергается процессам брожения и гниения.
- Гормональный дисбаланс, который чаще проявляется среди женской половины населения.
- Нехватка в организме железа и витаминов группы В.
- Патологии крови, для которых характерны быстрые деструктивные процессы, в результате которых эритроциты полностью утрачивают свои биологические функции.
Как проявляется?
 Пациенту, у которого понижен RDW, будут присущи все симптомы анемии:
Пациенту, у которого понижен RDW, будут присущи все симптомы анемии:
- вялость и апатия;
- быстрая утомляемость;
- частые головокружения, особенно при резких движениях;
- постоянная усталость даже после длительного отдыха;
- сильная одышка с присоединением грудного сухого кашля без причины;
- учащение сердцебиения (тахикардия);
- повышение артериального давления (при наличии избыточного веса).
Такие клинические проявления достаточно легко объяснить. Маленькие по размеру клетки приносят тканям и органам меньшее количество кислорода, от чего последние начинают страдать, поскольку все естественные биологические процессы (окисление и восстановление) без кислорода не происходят. Большие же, вообще не способны задерживать на своей поверхности молекулы кислорода, откуда и развивается микроцитарная анемия.
Первыми начнут страдать нервные клетки, отвечающие за все импульсы в организме, откуда и появляются вышеуказанные симптомы.
Что предпринять?
На консультации у врача, скорее всего он попросит пересдать анализ, поскольку индекс распределения эритроцитов практически не бывает понижен. Это значит, что все клетки идеальные по своим параметрам, чего не может быть в принципе
Если же исключены все факторы, которые бы могли повлиять на неточность результатов и показатель повторился, проводят полное обследование организма, отдавая особое внимание онкологическим исследованиям
Профилактика
 Предотвратить данный процесс можно, соблюдая несложные правила:
Предотвратить данный процесс можно, соблюдая несложные правила:
- Сбалансировано питаться, включая много свежих овощей, фруктов и нежирного мяса.
- Чаще бывать на свежем воздухе.
- Вести активный образ жизни.
- Не пренебрегать плановыми медосмотрами, где по статистике чаще всего выявляются серьезные патологии, не имеющие внешних признаков.
Таким образом, индекс распределения эритроцитов показывает их величину относительно друг друга, что позволяет определить их биологическую ценность. Пониженные показатели встречаются крайне редко, однако могут полностью указывать на наличие различных заболеваний. Индекс определяется при общем анализе крови, но полноценную силу имеет только при совместном вычислении с индексом MCV, показатели которых между собой взаимосвязаны.
Эта процентная величина относительная, поэтому во многих случаях не исчисляется при развернутом анализе крови.
Пониженный и повышенный уровни
 Ситуация, при которой RDW повышен, то есть имеем в наличии красные кровяные клетки большего, чем нужно объема, достаточно опасна. Дело в том, что одним из основных недостатков макроцитов является их укороченное время жизни. Само по себе это плохо, поскольку нужно как-то поддерживать общее количество эритроцитов в норме.
Ситуация, при которой RDW повышен, то есть имеем в наличии красные кровяные клетки большего, чем нужно объема, достаточно опасна. Дело в том, что одним из основных недостатков макроцитов является их укороченное время жизни. Само по себе это плохо, поскольку нужно как-то поддерживать общее количество эритроцитов в норме.
Но еще важнее, что увеличивается количество одномоментно распадающихся красных клеток и в результате увеличивается поток высвободившихся железа, билирубина. Этот увеличенный поток начинает загружать печень, которая теперь работает с перегрузкой.
Ко всему прочему часть макроцитов по своему диаметру не в состоянии протиснуться по диаметру капилляров и к их утилизации подключается селезенка. Нагрузка на нее приводит к ее увеличению в размерах, и селезенка начинает надавливать на кишечник и желудок. Могут пострадать окружающие ткани и органы.
Увеличение значений RDW более 15% указывает на развитие в организме патологических состояний. Наиболее часто RDW повышен бывает при:
- Сочетание с высокими показателями MCV при повышенном RDW – поражение печении при алкоголизме, гемолитическая анемия, мегалобластная анемия, гиповитаминоз витамина А.
- Сочетание с низкими показателями MCV при повышенном RDW – низкий уровень гемоглобина, железодефицитные состояния, самые начальные проявления талассемии.
- Сочетание с нормальными показателями MCV при повышенном RDW – манифестация железодефицитной анемии, понижение витамина В12 и/или фолиевой кислоты, что приводит к макроцитарной анемии.
Снижение показателей RDW ниже 10,2% встречается при наличии следующих патологических процессов в организме:
- Микроцитарная анемия.
- Ревматоидные артриты.
- Дефицит витамина В6.
- Кровопотеря.
- Нарушение всасываемости железа.
- Паразитарные инвазии.
При нормальных показателях RDW, сопровождающихся понижением MCV, говорят о:
- Частых переливаниях крови, при которых наблюдается диссоциация в образовании и наличии форменных элементов крови.
- Выраженной талассемии.
- Геморрагических процессах вследствие хронических кровопотерь, на которые организм человека не реагирует в начале заболевания никакими внешними проявлениями.
- Удалении селезенки вследствие травматических повреждений – при этом наблюдается резкое перераспределение клеток крови, а также задержка в образовании кровяных элементов из-за отсутствия одного из важных органов кроветворения.
- Злокачественных новообразованиях, при которых происходит угнетение клеточного роста системы крови.
- Проведенной химиотерапии, где, как и при проведении химиотерапевтического лечения наблюдается супрессия клеточных элементов системы крови.
- Развитие миелодисплазии.
Важно! Очень часто дебют различных заболеваний упускается ввиду недостаточной диагностики.
Своевременное, полное, а главное грамотное исследование, в первую очередь, показателей крови расскажет врачу о многих изменениях в организме человека. Это не позволит пропустить начало многих заболеваний, даже таких, как злокачественные новообразования различной локализации.
Соотношение с MCV
В лечении анемий и других заболеваний крови число RDW связано с MCV ‒ средним объёмом кровяных телец. По сути, RDW ‒ это коэффициент MCV. Его повышенное значение отображает большую неоднородность MCV (аницитоз), что обычно происходит при деградации или расстройстве созревания кровяных телец.
Сопоставление двух показателей даёт специалистам информацию о том или ином отклонении в состоянии крови. Разные комбинации значений RDW и MCV могут свидетельствовать об анемиях, талассемии, хронических болезнях печени.
Повышенное число RDW
- При нормальном MCV могут быть диагностированы ранняя железодефицитная анемия, заболевания печени, серповидно-клеточные болезни.
- Пониженный уровень свидетельствует о железодефицитной анемии, некоторых формах талассемии.
- При высоком значении диагностируются мегалобластная анемия (недостаток витамина B12, фолиевой кислоты), миелодиспластический синдром, хронические болезни печени.
Нормальный показатель RDW
- При низком MCV могут быть выявлены аномальный Е гемоглобин или малокровие как симптом хронического заболевания.
- Высокое значение возникает во время химиотерапии, при хронических расстройствах в работе печени, миелодисплазии.

Как и для чего проводится анализ
Самый обычный и, пожалуй, самый распространенный общий анализ крови позволяет проанализировать много показателей, с помощью которых можно без труда выявить то или иное отклонение от нормы. Человеческая кровь на RDW исследуется тогда, когда пациент проходит плановое обследование или, например, для диагностики различного рода патологических состояний. Предложение о сдачи крови для определения данного показателя может последовать от специалиста и в том случае, если имеются какие-либо подозрения на наличие анемии.
Чтобы определить показатель RDW, пациенту необходимо сдать кровь из вены в небольшом количестве. Однако кровь может быть взята и из пальца, особенно если речь идет о маленьком ребенке.
Соблюдение, каких правил необходимо перед прохождением исследования:
- Забор крови осуществляется только в утренние часы, поэтому в лабораторию подойти лучше заранее.
- Сдавать анализ нужно только на голодный желудок, запрещается пить даже чай, единственное, что можно, так это чистую негазированную воду.
- Накануне сдачи крови лучше всего отказаться от любых физических нагрузок.
Правила достаточно простые, поэтому при их соблюдении вы не ощутите какого-либо дискомфорта. Весь полученный материал собирается с помощью специальной трубочки и помещается в изолированный контейнер, где и хранится до начала тщательного исследования.
Необходимо учитывать и то, что существует два показателя RDW – это RDW CV и RDW SD. Оба этих показателя что CV, что SD предопределяют вариативность красных кровяных телец по их величине. Если вы получили на руки результаты анализов и при попытке самостоятельной расшифровки увидели там, например, такой показатель, как RDW CV или PCT, не стоит удивляться. Человеку непосвященному что первая, что вторая аббревиатура мало что скажет, а вот опытный специалист быстро определит, повышена, понижена она или в норме.
Понижение уровня RDW
Чтобы разобраться в причинах пониженного показателя RDW, необходимо пересмотреть две вариации низкого показателя при соотношении двух индексов – RDW и MCV.
Первая ситуация – RDW низкий, а MCV – меньше среднего. Это сигнализирует о патологиях печени либо селезенки.
Видео:
Вторая – RDW низкий, а MCV выше нормального – развитие злокачественных новообразований, вероятно, с метастазированием в костномозговую ткань.
Понижение показателя распределения красных клеток не проявляется симптоматично, поэтому в традиционной медицине при обнаружении очень низкого уровня практически всегда назначается повторное исследование крови, но с соблюдением обязательных условий:
- не употреблять спиртосодержащие напитки;
- не курить;
- не принимать лекарственные препараты;
- исключить из рациона жирную, жареную, соленую, острую и копченую пищу;
- ограничить физические нагрузки.
Если при получении повторного результата анализа оказывается, что показатели RDW и MCV неудовлетворительны, то это может сигнализировать о развитии таких патологий:
- гипохромная анемия – так называемое малокровие, вызванное преждевременной гибелью эритроцитов;
- онкологические патологии – рак молочной железы, спинного мозга;
- обширный гемолиз – заболевание, при котором красные клетки крови разрушаются настолько рано, что не приносят для организма человека пользы.

Причины, способные спровоцировать понижение RDW:
- потеря значительного количества крови при ранениях и повреждениях. Самые опасные внутренние кровотечения – это маточное и желудочно-кишечное, при которых возникает риск не только для здоровья, но и для жизни пациента;
- операбельные вмешательства, особенно из-за резекции;
- патологии пищеварительной системы, при которых пища не переваривается в полной мере, а провоцирует процесс гниения;
- гормональные колебания;
- авитаминоз;
- заболевания крови.
Предотвратить снижение показателя индекса распределения эритроцитов можно, причем сделать это довольно просто.
Во-первых, рекомендуется правильно и рационально питаться, отдав предпочтение большому количеству свежих овощей, ягод и фруктов, постному мясу и рыбе.
Во-вторых, необходимо больше времени уделять активному спорту – пробежки, велопрогулки, и даже пешие прогулки на свежем воздухе принесут большую пользу организму.

Не стоит игнорировать необходимость посещения медицинского учреждения для планового обследования.
По статистике именно на плановых осмотрах диагностируются многие заболевания, не проявляющиеся симптомами.
Эритроциты, их функции в организме, основные показатели
Эритроциты, или красные кровяные тельца (RBC, red blood cells), – это красные кровяные тельца, клетки крови двояковогнутой дисковидной формы, лишенные ядра. Форма эритроцита позволяет клетке деформироваться при продвижении через кровеносные сосуды малого калибра. Основной функцией эритроцитов является транспорт кислорода от легких к тканям и органам, а от них – углекислого газа в легкие. Эритроциты образуются в костном мозге и разрушаются в селезенке, средний срок жизни клеток составляет 120 суток. У новорожденных размер эритроцитов больше, чем у взрослых.
Состояние, при котором в крови определяются эритроциты аномальных размеров, называется анизоцитозом
Состояние, при котором в крови определяются эритроциты аномальных размеров, называется анизоцитозом
Физиологическое увеличение количества эритроцитов наблюдается у детей первых дней жизни, при частых стрессах, интенсивных физических нагрузках, недостаточном питании или голодании, при длительном пережатии конечности жгутом во время взятия крови для проведения анализа крови. Физиологическое уменьшение количества красных кровяных телец происходит сразу после еды, в промежуток времени между 17:00 и 07:00 и в случае взятия крови у пациента в положении лежа.
В крови, помимо нормальных эритроцитов, могут присутствовать клетки, отличающиеся размерами – более крупные (макроциты) или мелкие (микроциты) красные кровяные тельца. Состояние, при котором в крови находится более 50% макроцитов, называется макроцитозом. При наличии 30–50% микроцитов диагностируется микроцитоз. Появление в крови различающихся по объему эритроцитов называется анизоцитозом, степень которого позволяет определить индекс RDW.
Эритроцитарные индексы определяются в ходе общего (клинического) анализа крови. Подсчет осуществляется при помощи автоматического гематологического анализатора, по соответствующим формулам и/или в окрашенном мазке крови под микроскопом при подсчете лейкоцитарной формулы. К эритроцитарным индексам в общем анализе крови, помимо RDW, относятся MCV (средний объем эритроцита), MCH (среднее содержание гемоглобина в эритроците), MCHC (средняя концентрация гемоглобина в эритроцитарной массе).
Повышенный показатель
Высокий уровень RDW в результате анализа крови может быть свидетельством болезни или патологии. Часто показатель отличается от нормы вследствие нехватки тех или иных питательных веществ и витаминов. Основные причины нарушения:
Онкологические заболевания, развитие опухолей
Заболевания печени в хронической стадии
Болезнь Альцгеймера
Заболевания сердечно-сосудистой системы
Анемии различной природы (гемолитическая, микроцитарная, мегалобластная, железодефицитная), среди всех пациентов особенно важно выявить это состояние у беременных женщин
Дефицит железа, который влияет на кроветворную функцию
Дефицит витаминов В9 и В12
Недостаток фолиевой кислоты
Алкоголизм
RDW в анализе крови повышен

Эритроцитарный коэффициент RDW-SD в анализе крови расшифровывается как относительная ширина распределения эритроцитов по объему (стандартное отклонение). Если при пониженном MCV показатель RDW повышен, то это может свидетельствовать о бета-талассемии, дефиците железа, фрагментации эритроцитов.
Индекс RDW отражает неоднородность эритроцитов, является мерой несхожести популяции эритроцитов по объему и указывает на отклонения в объеме красных кровяных клеток. Он показывает, как сильно данные клетки несхожи по размеру и объему, то есть, какое отличие между крошечным эритроцитом и очень большим.
Если в анализе ширина распределения эритроцитов ниже нормы, то этот факт говорит о необходимости пересдачи анализов. Проще говоря: эритроциты вашей крови могут иметь разный размер, и чтобы выяснить насколько они разнятся, используется показатель RDW-CV.
Ширина распределения эритроцитов измеряется в процентах и нормой считается показатель от 11,5 до 14,8. Данный показатель может выявить, например, наличие латентного железодефицита у ребенка.
SD — стандартное среднеквадратическое отклонение объема эритроцита от среднего значения.
С помощью этого исследования определяют присутствие в крови красных клеток, значительно превышающих по объему среднее значение, и разницу между большими и маленькими клетками.
Это связано с тем, что в крови много видоизмененных эритроцитов, называемых макроцитами. Здоровый человек в составе крови содержит эритроциты, которые одинаковые по размеру, а также форме и окраске.
Анализ крови на RDW: что это такое?
Средний объем эритроцитов характеризуется параметром MCV. У здорового человека такой показатель граничит в маленьких пределах.
Современный анализатор устанавливает средний объем эритроцита, а также степень отклонения от нормы этого параметра. Гетерогенность эритроцитов – это появление в крови различных по объему красных телец.
Но вот их преобладающее количество свидетельствует о тех или иных заболеваниях.
Гетерогенность эритроцитарных показателей в норме
С расшифровкой RDW в анализе крови ситуация немного прояснилась, но это только верхушка айсберга. Существует два показателя RDW. Это RDW-CV и RDW-SD – они оба предопределяют вариативность красных кровяных клеток по величине. На RDW-CV в анализе крови влияет MCV, при колебаниях которого будет наблюдаться склонность к увеличению описываемого показателя.
Суть RDW анализа крови
Повышение RDW более чем на 15% говорит о наличии неоднородных по объему клеток (микро-, нормо-, макро- и шизоцитов). Чем выше показатель, тем больше расхождения в размерах красных клеток.
Спасибо. Теперь в целом ничего не понятно — RCB и гемоглобин понижен, MCV и MCH повышены, а RDW в норме. Непонятно.
Повышенные значения RDW характеризуют образцы крови с эритроцитами, сильно отличающимися по размеру, от мелких до крупных (анизоцитоз). Расшифровка данной аббревиатуры – «распределение эритроцитов по величине». Эритроциты – это красные тельца двояковогнутой дисковидной формы, окрашивающие кровь в соответствующий цвет. Они составляют основу крови и снабжают кислородом ткани и органы.
В каких случаях проводят анализ?
Его средний показатель обозначается MCV. У здоровых людей это значение может колебаться в незначительных пределах. Обычно красные клетки уменьшается в объеме с возрастом человека, таким образом, между ними появляется разница. Могут предложить сдать кровь на этот показатель, если есть подозрения на анемию.
Появление в крови эритроцитов, разных по объему, называется анизоцитозом. В принципе, ширина распределения эритроцитов пониженной быть не может, и такой результат не является диагностически ценным.
В данном посте пойдет разговор о таком показателе как RDW в анализе крови, или ширине распределения эритроцитов, что определяется большинством современных приборов. По результатам анализа крови — эритроциты 4,69. RDW-SD 44.4fl, RDW-CV 0.
128. В прочих изменениях анизоцитоз.
все песни RDV DJ
-
Прослушать
скачатьдобавить в избранное
03:03RDV DJ
БРИБУМЕР 2 -
Прослушать
скачатьдобавить в избранное
03:12Rdv Dj
Брибумер -
Прослушать
скачатьдобавить в избранное
03:17RDV-DJ
Star Wars Theme -
Прослушать
скачатьдобавить в избранное
03:18RDV DJ
звёздные войны(remix) -
Прослушать
скачатьдобавить в избранное
03:12RDV DJ
Брибумер (Бригада+Бумер) -
Прослушать
скачатьдобавить в избранное
03:12RDV-DJ
Прибумер -
Прослушать
скачатьдобавить в избранное
03:37RDV DJ
Трах -
Прослушать
скачатьдобавить в избранное
03:17RDV-DJ
Star Wars Theme (Да пребудет с тобой сила!) -
Прослушать
скачатьдобавить в избранное
03:11RDV DJ
BriBumer (Brigada vs Bumer) -
Прослушать
скачатьдобавить в избранное
03:12RDV DJ
RDVDJ_-_Bribumer -
Прослушать
скачатьдобавить в избранное
03:11Rdv dj
Брибумер -
Прослушать
скачатьдобавить в избранное
03:12RDV DJ
БриБумер — 2 -
Прослушать
скачатьдобавить в избранное
06:28RDV DJ
Ibiza Drams -
Прослушать
скачатьдобавить в избранное
04:26RDV DJ
БриБумер (2 Club Remix) -
Прослушать
скачатьдобавить в избранное
03:40RDV DJ
Chungafaction -
Прослушать
скачатьдобавить в избранное
03:14RDV DJ
брибумер2 -
Прослушать
скачатьдобавить в избранное
03:17RDV Dj
Star Wars Theme -
Прослушать
скачатьдобавить в избранное
02:30RDV DJ
БриБумер-2 -
Прослушать
скачатьдобавить в избранное
03:13RDV DJ
БРИБУМЕР 2 -
Прослушать
скачатьдобавить в избранное
03:16Rdv DJ
Starwars Theme -
Прослушать
скачатьдобавить в избранное
03:18RDV DJ
StarWars Theme -
Прослушать
скачатьдобавить в избранное
03:17RDV_DJ
StarWars_Theme -
Прослушать
скачатьдобавить в избранное
03:15Rdv Dj
StarWars Theme -
Прослушать
скачатьдобавить в избранное
03:10RDV Dj
StarWars Theme -
Прослушать
скачатьдобавить в избранное
00:33RDV DJ
Брибумер -
Прослушать
скачатьдобавить в избранное
04:00RDV DJ
IBIZA DREAM -
Прослушать
скачатьдобавить в избранное
00:49RDV-DJ
.muzhit.ru -
Прослушать
скачатьдобавить в избранное
04:27RDV DJ
Брибумер-2 club remix -
Прослушать
скачатьдобавить в избранное
03:20RDV DJ
Star Wars Theme (Звёздные войны) -
Прослушать
скачатьдобавить в избранное
02:56RDV DJ
Убойный Петербург -
Прослушать
скачатьдобавить в избранное
03:35RDV DJ
Чунга-Чанга (remix) Песенка про моего Папу -
Прослушать
скачатьдобавить в избранное
03:20Rdv Dj
Hi Dook -
Прослушать
скачатьдобавить в избранное
03:17RDV DJ
Star Wars 2005 -
Прослушать
скачатьдобавить в избранное
03:12RDV DJ
Брибумер (Electro Makerz Remix) -
Прослушать
скачатьдобавить в избранное
03:10RDV DJ
Брибумер -
Прослушать
скачатьдобавить в избранное
03:38RDV DJ
День Победы -
Прослушать
скачатьдобавить в избранное
03:20RDV Dj
HiDook -
Прослушать
скачатьдобавить в избранное
03:38RDV DJ
Chungafaction -
Прослушать
скачатьдобавить в избранное
04:38RDV DJ
RUNAWAY -
Прослушать
скачатьдобавить в избранное
03:01RDV DJ
Бандитский Петербург -
Прослушать
скачатьдобавить в избранное
02:48RDV DJ
Последняя композиция -
Прослушать
скачатьдобавить в избранное
02:18RDV_DJ
Малинки MIX (DJ VIP MC) -
Прослушать
скачатьдобавить в избранное
03:11RDV DJ
BriBumer-2 -
Прослушать
скачатьдобавить в избранное
03:37RDV DJ
Футбольный гимн -
Прослушать
скачатьдобавить в избранное
03:38RDV DJ
ЧунгаФэкшн -
Прослушать
скачатьдобавить в избранное
03:13RDV DJ
Briboomer (mix) -
Прослушать
скачатьдобавить в избранное
02:57RDV DJ
Бандитский Петербург (Remix) -
Прослушать
скачатьдобавить в избранное
03:26RDV_DJ
Малинки MIX (DJ VIP MC) -
Прослушать
скачатьдобавить в избранное
03:11RDV DJ
BriBumer -
Прослушать
скачатьдобавить в избранное
03:11RDV DJ
Брибумер-2
- 1
- →
Анализ параметров эритроцитов
Большинство параметров, проводимого анализа крови понятны пациентам. Такие показатели как лейкоциты, глюкоза, холестерин и другие хорошо знакомы, а их нормальный уровень указывается рядом с результатом пациента. Простое математическое сравнение цифр позволяет убедиться, что анализы находятся в пределах нормы. Но что такое RDW?

RDW анализ крови и индекс распределения эритроцитов одна и та же величина. Исследуется наличие деформированных красных кровяных телец (анизоцитоз эритроцитов), а показатель отражает однородность эритроцитов. В нормальном состоянии красные кровяные тельца должны быть приблизительно одного размера, чтобы при необходимости один эритроцит заменял собой другой и выполнял те же функции.
Для их существования требуется больше питания, а продолжительность их жизни сокращается. Также макро клетки часто больше по размеру, чем диаметр капилляров и не могут циркулировать по кровеносной системе, они утилизируются.
RDW тест крови позволяет определить соотношение деформированных или увеличенных красных кровяных телец и эритроцитов нормального размера. Выделяют два типа показателей RDW CV и RDW SD. Первая величина (RDW CV в анализах крови) показывает процентное распределение клеток по величине. Вторая отражает их стандартное отклонение, то есть разницу по размеру между самым маленьким и самым большим из присутствующих в образце крови эритроцитов.
Значение RDW
Ширина распределения рассчитывается во время общего анализа венозной крови, чтобы определить однородность эритроцитов. Слово «ширина» в этом термине иногда вводит в заблуждение. RDW обозначает вариацию в размерах эритроцитов. Такое значение вычисляется сравнением их объёма.

Электронные приборы способны оценивать импульсы, которые продуцируют кровяные тельца. Чем сильнее импульс, тем больше эритроцит. Приблизительная вариация размеров здоровых эритроцитов составляет 10,2‒14,6%
Важно учесть, что при использовании разных аппаратов расшифровка RDW может отличаться, поэтому на результате теста указывается справочное значение нормы

Comments
(0 Comments)